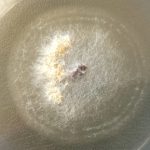

2 ақпан 2026
- УНИВЕРСИТЕТ
- Білім
- Академиялық саясат
- Университеттің академиялық Кеңесі
- Білім беру бағдарламалары
- Нормативтік-құқықтық база
- Дуалды оқыту
- Кәсіби практика
- Ресурстық орталық
- Университеттің әдістемелік жұмысы
- Minor қосымша білім беру бағдарламасы
- Микробіліктілік бағдарламалары
- Инклюзивті білім беру
- Жоғары оқу орнының үздік оқытушысы
- Ғылым
- Ғылыми зерттеу қызметі
- Ғылымның басым бағыттары
- Ғылыми мектептер
- Қызметкерлердің патенттері мен авторлық құқықтары
- Нормативтік актілер
- Жарияланым белсенділігі
- Құжаттар
- Зияткерлік меншік және инновация
- С.Аманжолов атындағы ШҚУ ғылыми-зерттеу жұмыстарының серіктес кәсіпорындар
- Инновациялық қызмет
- Алынған ғалымдардың патенттері
- Авторлық куәліктер және аккредиттеу
- START UP — академиясы
- Ғылыми және (немесе) ғылыми-техникалық жобалар бойынша ақпарат
- Студенттердің ғылыми-зерттеулері
- Ғылыми орталықтар мен зертханалар
- AU ғылыми басылымдары
- Диссертациялық кеңес
- Қорғау туралы ақпарат
- Ережелер
- Диссертациялық Кеңес туралы үлгі ереже
- Диссертациялық Кеңес туралы ереже
- Қарыз алуды анықтаудың лицензиялық жүйесінің болуы туралы мәліметтер 2024
- Қарыз алуды анықтаудың лицензиялық жүйесінің болуы туралы мәліметтер 2025
- Қарыз алуды анықтаудың лицензиялық жүйесінің болуы туралы мәліметтер 2026
- Зерттеуші ғалымның Этика кодексі туралы ереже
- Дәрежелерді беру қағидалары
- Диссертациялық кеңес
- Жас ғалымдар кеңесі
- Аманжолов университеті хабаршысы
- Ғылыми зерттеу қызметі
- ТАЛАПКЕРГЕ
- СТУДЕНТТЕРГЕ
- РЕСУРСТАР
- Халықаралық қызмет
- ТДМ
- AI-SANA
- ЖОҒАРЫ МЕКТЕПТЕР
- ЖОҒАРЫ КОЛЛЕДЖ